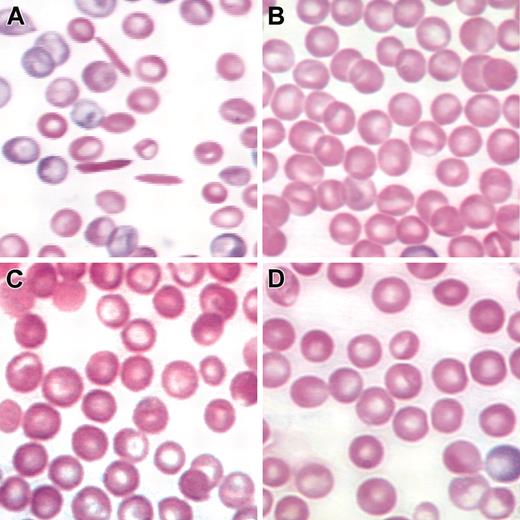

Abstract
Although sickle cell anemia was the first hereditary disease to be understood at the molecular level, there is still no adequate long-term treatment. Allogeneic bone marrow transplantation is the only available cure, but this procedure is limited to a minority of patients with an available, histocompatible donor. Autologous transplantation of bone marrow stem cells that are transduced with a stably expressed, antisickling globin gene would benefit a majority of patients with sickle cell disease. Therefore, the development of a gene therapy protocol that corrects the disease in an animal model and is directly translatable to human patients is critical. A method is described in which unmobilized, highly purified bone marrow stem cells are transduced with a minimum amount of self-inactivating (SIN) lentiviral vector containing a potent antisickling β-globin gene. These cells, which were transduced in the absence of cytokine stimulation, fully reconstitute irradiated recipients and correct the hemolytic anemia and organ pathology that characterize the disease in humans. The mean increase of hemoglobin concentration was 46 g/L (4.6 g/dL) and the average lentiviral copy number was 2.2; therefore, a 21-g/L /vector copy increase (2.1-g/dL) was achieved. This transduction protocol may be directly translatable to patients with sickle cell disease who cannot tolerate current bone marrow mobilization procedures and may not safely be exposed to large viral loads. (Blood. 2003;102:4312-4319)
Introduction
Sickle cell disease (SCD) is an autosomal recessive disorder that affects more than 300 000 individuals worldwide and more than 70 000 in the United States. The molecular basis of the disease is an A>T transversion in the sixth codon of the β-globin gene.1,2 This mutation results in the substitution of a valine residue for glutamic acid on the surface of hemoglobin S (HbS; α2β2S) tetramers. The valine creates a hydrophobic projection that fits into a natural hydrophobic pocket formed on hemoglobin tetramers after deoxygenation.3,4 The interaction of tetramers results in the formation of HbS polymers/fibers that cause red blood cells (RBCs) to become rigid and nondeformable and to occlude small capillaries.5-10 These vaso-occlusive events cause severe tissue damage that can result in strokes, splenic infarction, kidney failure, liver and lung disorders, painful crises, and other complications.11,12 Cycles of erythrocyte sickling also cause the cells to become fragile, and lysis produces chronic anemia. Although sickle cell anemia was the first hereditary disease to be understood at the molecular level,1,2 there is still no adequate long-term treatment or cure. Current measures focus on induction of fetal hemoglobin to inhibit polymer formation, treatment and prevention of infections, palliative measures to control pain, and surgical treatment of complications.12 Allogeneic bone marrow transplantation is the only available cure, but this procedure is limited to a minority of patients with an available, histocompatible donor.13
Autologous transplantation of bone marrow stem cells that are transduced with a stably expressed, antisickling globin gene would benefit a majority of patients with SCD. Recently, several groups have used lentiviral vectors for globin gene transfer to bone marrow mononuclear cells and this work has resulted in the correction of sickle cell anemia and β-thalassemia in relevant mouse models of these human diseases.14-17 Although these studies represent major advances in gene therapy for hemoglobinopathies, the transduction protocols that were used cannot be directly translated to human patients. In all of the cases referenced above, donor bone marrow cells were mobilized by treating the mice with 5-fluorouracil (5-FU). The equivalent treatment in humans is mobilization of hematopoietic stem cells (HSCs) with granulocyte colony-stimulating factor (G-CSF) or stem cell factor (SCF) or both. This treatment is effective for mobilizing bone marrow HSCs into peripheral blood and these HSCs successfully engraft in recipients.13 Unfortunately, G-CSF cannot be used safely in patients with SCD. Abboud et al18 have described severe sickle cell crisis in a patient receiving G-CSF, and Adler et al19 reported the death of a patient with SCD whose bone marrow was mobilized with G-CSF. This latter patient was 47 years old and had no previous history of sickle cell crisis. SCF, which has also been used to mobilize bone marrow, is associated with anaphylaxis and other serious adverse effects that preclude its use in a transplantation protocol for sickle cell patients.20
Another difficulty with the transduction protocol used in recent gene therapy studies for hemoglobinopathies is the ex vivo stimulation of HSCs with cytokines. This treatment is included in the protocols to increase the number of stem cells that are actively progressing through the cell cycle and, therefore, to increase the efficiency of retroviral or lentiviral transduction. Unfortunately, cytokine stimulation of HSCs and premature exit from quiescence can decrease self-renewing capacity, homing efficiency, and, therefore, long-term engraftment in mice and in humans.21-25 Although retroviral transduction requires cell division,26,27 efficient lentiviral transduction can occur in quiescent cells.28-31 We recently demonstrated that unmobilized HSCs derived from murine bone marrow are efficiently transduced with a lentiviral vector in the absence of cytokine stimulation and that the transduced gene is expressed in all hematopoietic cell lineages examined for at least 5 months after transplantation into lethally irradiated recipients.32 These results suggest that quiescent, unmobilized HSCs are efficiently transduced by lentiviral vectors without impairing self-renewal and normal lineage specification in vivo. Therefore, the protocol that we have adopted for our globin gene transfer studies does not include cytokine stimulation.
A final problem with the lentiviral transduction protocols used previously is the large amount of virus used. Several million bone marrow mononuclear cells are transduced at a multiplicity of infection (MOI) of 60 or more and transplanted into recipients; therefore, each animal is exposed to more than 1 × 108 lentiviral particles.15,16 Replication-defective lentiviral vectors appear to be safe in animal models; however, clinical trials in humans will most likely be approved only for protocols using minimal amounts of virus. Therefore, we have developed a protocol that exposes the animals to at least 3000 times less lentiviral vector than previous protocols by transducing highly purified HSCs (Sca-1+, c-Kit+, Lin-/low) at an MOI of approximately 30.
Materials and methods
Antisickling lentiviral vector design and production
A 2.3-kb recombinant human βAS3 gene (T.M.R. et al, unpublished, May 1995) and 3.4 kb of human β-globin locus control region (LCR) sequences were subcloned into pWPT-GFP (a kind gift from Dr Didier Trono) replacing the EF1α promoter and green fluorescent protein (GFP). This self-inactivating (SIN) vector contains a deletion in the U3 region of the 3′ long terminal repeat (LTR) from nucleotide 418 to nucleotide 18 that inhibits all transcription from the LTR.33 The βAS3-globin gene contains 266 bp of promoter, the 260-bp PstI 3′ globin enhancer,34 and a 375-bp RsaI fragment deletion of IVS2.35 DNase I hypersensitive site (HS) fragments, 5′ HS4, 3, and 2 were amplified by polymerase chain reaction (PCR) from a 22-kb fragment of the LCR.36,37 Nucleotide coordinates from GenBank accession no. U01317 are: HS4 592-1545, HS3 3939-5151, and HS2 8013-9215. The entire HS4, 3, 2 βAS3-globin gene construct was verified by sequencing. Vectors were produced by transient transfection into 293T cells as previously described38 with the following modifications. A total of 2.5 × 106 293T cells were seeded in 10-cm-diameter dishes containing Dulbecco modified Eagle medium (DMEM) with 10% fetal bovine serum (FBS) 24 hours prior to transfection. Forty micrograms plasmid DNA was used for transfection of one 10-cm dish. The DNA cocktail contained 5 μg envelope-coding plasmid pMD.G, 15 μg of the packaging plasmid pCMVDR8.91 (which expresses Gag, Pol, Tat, and Rev) and 20 μg SIN transfer vector plasmid. Transfection medium was removed after 14 to 16 hours and replaced with DMEM/F12 without phenol red (Invitrogen, Carlsbad, CA) containing 2% FBS. Viral containing supernatant was collected after an additional 24 hours, cleared by low-speed centrifugation, and filtered through a low protein-binding 0.22-μm polyethersulfone filter (Millipore, Beford, MA). The virus was concentrated 1000-fold by one round of centrifugation at 26 000 rpm for 90 minutes at 8°C using an SW-28 rotor (Beckman, Palo Alto, CA), resuspended into serum-free stem cell growth medium (SCGM) (Cellgenix, Freiburg, Germany) and allowed to incubate on ice for 2 hours before storage at -80°C. Virus titer was determined by infecting murine erythroleukemia (MEL) cells, plating individual cells into wells of a 96-well plate, and assaying DNA from the cultures by PCR for the human βAS3-globin gene.
Murine bone marrow cell preparation and stem cell sorting
HSCs from our SCD mice39 were obtained as previously described with minor modifications.32 Briefly, bone marrow cells were flushed from the femurs and tibias of SCD mice and stained with a biotinylated Sca-1 antibody (clone E13-161.7; BD-Biosciences, San Diego, CA) followed by an antibiotin magnetic bead (Miltenyi Biotec, Auburn, CA) and fluorescein isothiocyanate (FITC)-conjugated streptavidin (Caltag, Burlingame, CA). Sca-1 cells were then isolated on a magnetic-activated cell sorter (MACS; Miltenyi Biotec). The Sca-1-enriched cells were then stained with phycoerythrin (PE)-conjugated antibodies directed against lineage antibodies CD3, 145-2C11; CD4, RM4-5; CD5, 53-7.3; CD8, 53-6.7; CD11b (Mac-1), M1/70; Gr-1, RB6-8C5; CD45RA, RA3-6B2; and TER119/Ly-76, TER119 (BD-Biosciences) followed by staining with allophycocyanin (APC)-conjugated c-Kit (clone 2B8; BD-Biosciences). Cells were washed once and resuspended in Iscove modified Dulbecco medium (IMDM) containing 2% FBS for fluorescence-activated cell sorting (FACS) on a FACSVantage SE (BD-Biosciences) flow cytometer. Sca-1+c-Kit+Lin-/low cells were collected into IMDM containing 1% FBS for transduction.
Purification of bone marrow Ter119+ and CD11b(Mac-1)+ and Gr1+ cells from secondary transplants was accomplished by staining bone marrow mononuclear cells with PE-conjugated antibodies directed against Ter119 or against CD11b(Mac-1) and Gr1 and sorting on a FACSVantage SE (BD-Biosciences) flow cytometer. DNA was obtained from approximately 1 × 105 purified cells using the Qiagen (Valencia, CA) DNeasy kit.
Congenic knockout-transgenic sickle mice and HSC preparation
Congenic knockout-transgenic (KO-TG) SCD mice were generated from line HbS539 by backcrossing mouse α-globin knockout,40 mouse β-globin knockout,41 and LCRα/LCRAγβs transgenic39 mice to the C57Bl/6 (B6) strain in parallel. After 8 successive backcross generations these 3 B6 congenic lines were interbred to generate KO-TG-B6 SCD mice that synthesize solely human hemoglobin in their adult RBCs. These backcrosses were performed to inhibit graft-versus-host reactions in long-term reconstituted recipients. The animals are extremely anemic on the C57Bl/6 background; hemoglobin levels are as low as 23 g/L (2.3 g/dL). Both the HbS5 and HbS3 lines that we originally reported39 were backcrossed onto C57Bl/6. The HbS3 line, which has balanced α- and β-globin chains, was so severely anemic on the C57Bl/6 background that the line could not be used for these experiments. The HbS5 line is slightly β-thalassemic, similar to the BERK mice,42 and survives longer on the C57Bl6/background. Therefore, we used this line for these studies.
Stem cell transduction and transplantation
Sorted Sca-1+, c-Kit+, Lin-/low stem cells were resuspended in IMDM medium containing 10 μg/mL dextran sulfate and 1% FBS. One thousand stem cells were infected at an MOI of 30 in a total volume of 100 μL at 37°C in 5% CO2 for 4 hours. Mock- or lenti βAS3-transduced stem cells were injected into the retro-orbital sinus of anesthetized 8-week-old C57Bl/6 mice that were lethally irradiated (1325 cGy administered in a split dose). Hematopoietic reconstitution with donor HSCs from the sickle mice was monitored by analyzing the replacement of murine hemoglobin polypeptides with human hemoglobin polypeptides using high-performance liquid chromatography (HPLC) as described previously.39 Secondary transplantations were performed with one million unfractionated mononuclear cells isolated from primary transplants. The cells were injected into lethally irradiated C57Bl/6 mice and hemoglobin levels were analyzed 4 months after transplantation.
Lenti/βAS3 vector copy number determination
The lenti/βAS3 vector copy number in transplanted mice was determined by an allele-specific assay. Transplant bone marrow DNA was obtained using the Qiagen DNeasy kit. Bone marrow DNA was amplified by PCR with primers that anneal to identical sequences in the human βS- and βAS3-globin genes. These primers do not amplify mouse β-globin. The sequences of the forward and reverse primers are 5′-ACATTTGCTTCTGACACAACT-3′ and 5′-GGGAAAATAGACCAATAGGC-3′, respectively. Twenty-five cycles of PCR were performed with unlabeled primers followed by one cycle of primer extension with 5′ [32P]-labeled reverse primer. Twenty-five cycles of PCR were within the linear range of amplification. The resulting 264-bp amplicon was digested with Bsu36I that cuts only the βAS3-globin gene, producing a 194-bp restriction fragment. After complete digestion, the resulting radiolabeled fragments were separated on a 2% Tris-borate-EDTA (TBE; tris(hydroxymethyl)aminomethane; ethylenediaminetetraacetic acid) agarose gel. The copy number of the human βS allele was determined by the same method as for lenti/βAS3 except that βS-globin was compared to mouse β-globin in sickle animals that were heterozygous for the mouse β-globin knockout. Forward and reverse primers complementary to identical sequences in the mouse and human β-globin genes were 5′-ATGAAGTTGGTGGTGAGC-3′ and 5′-AGACTCACCCTGAAGTTCTC-3′, respectively. Twenty-seven cycles of PCR were performed with unlabeled primers followed by one cycle of primer extension with 5′ [32P]-labeled forward primer. Twenty-seven cycles of PCR were within the linear range of amplification. The resulting 389-bp amplicon was digested with SacI that cuts only the mouse β-globin gene, producing a 337-bp restriction fragment. Using this allele-specific PCR methodology to analyze transgene (LCRAγβs) copy number, we determined that the mice contain 3 copies of the human βS gene. DNA bands were quantified with a Molecular Dynamics Storm Phosphorimager (Amersham Biosciences, Piscataway, NJ) and the ratio of lenti/βAS3 to LCRAγβs was determined by IMAGE-QUANT software (Amersham Biosciences).
Globin protein analysis
Although the βAS3 polypeptide differs from βS by 4 amino acids, we were unable to discriminate the 2 species using HPLC. Therefore, hemoglobins were separated by isoelectric focusing (IEF) of hemolysates as described previously.43,44 Briefly, IEF was performed using the isothermal controlled electrophoresis system (Fisher Scientific, Pittsburgh, PA) with precast agarose IEF gels (Isolab, Akron, OH). Hemoglobin bands were quantitated by densitometry with a Bio-Rad (Hercules, CA) GS-800 scanner using Quantity One software. HbS and HbAS3 bands focused at the same isoelectric point as HbS and HbAS3 purified from transgenic/knockout mice that synthesize these hemoglobins exclusively. HbAS3 bands were also confirmed by tryptic digestion and analysis by matrix-assisted laser desorption/ionization time-of-flight (MALDI-TOF) mass spectrometry.
Single-cell expression level analysis
Analysis of mRNA levels was performed on peripheral blood reticulocytes isolated from animals receiving transplants with the lenti-βAS3 vector. Reticulocytes were stained with thiazole orange,45 purified on a FACScan flow cytometer (BD-Biosciences) and plated after limit dilution at one cell per 3 wells in a 96-well plate. Plates were stored at -80°C for 1 hour and cells were thawed into 2.5 μL lysis buffer (1.6% IGEPAL/NP-40; Sigma, St Louis, MO). Reverse transcription (RT) was performed with Superscript II RT (Invitrogen) according to manufacturer's recommendations. Two microliters of the RT reaction were used to perform PCR with ExTaq (Panvera-TaKaRa, Madison, WI). As described for gDNA PCR, the primers used for RT-PCR anneal to sequences that are identical in the human βS and human βAS3 globin genes. The forward primer sequence was 5′-ACATTTGCTTCTGACACAACT-3′ (5′ untranslated region) and the reverse primer was 5′-CCATAACAGCATCAGGAGTG-3′ (2nd exon). Thirty-five cycles of PCR were performed with unlabeled primers and then one cycle of primer extension was performed with 5′ γ-[32P]-labeled reverse primer. This cycle number was within the linear range of amplification. The resulting 222-bp PCR product was digested with Bsu36I that cuts βAS3 and yields a 151-bp fragment. After complete digestion, the resulting radiolabeled fragments were separated on an 8% acrylamide gel.
Hematologic indices and histopathology
Blood was collected from anesthetized animals into Microtainer EDTA collection tubes. RBC count was measured on a HemaVet 1500 hematology analyzer (CDC Technology, Oxford, CT). Hemoglobin concentration was determined spectrophotometrically after conversion to cyanmethemoglobin with Drabkin reagent (Sigma). Before determining the hemoglobin concentration, RBC membranes were pelleted at 14 000 rpm for 5 minutes in an Eppendorf centrifuge. Pelleting the membranes inhibits artifactually high values caused by membrane-bound, denatured hemoglobin. Packed cell volume (PCV) was measured with a JorVet J503 (Jorgenson Laboratories Systems, Loveland, CO) microhematocrit centrifuge. Reticulocyte count was determined by flow cytometry after staining with thiazole orange. Urine osmolality was measured with the Wescor Vapro Vapor Pressure Osmometer 5520 (Wescor, Logan, UT) after food and water were withheld from the mice for 4 hours. Tissues were fixed in 70% alcoholic formalin, embedded in paraffin, sectioned, and stained with hematoxylin-eosin or Gomori iron stain by standard methods.
Results
Insertion of potent antisickling gene into a lentiviral vector
We previously demonstrated that substitution of an alanine at position 22 and glutamine at position 87 of the human β-globin polypeptide (βAS2) significantly inhibits HbS polymerization.46 We have now introduced an additional modification that increases the affinity of β-globin subunits for α-globin polypeptides and results in a molecule that impedes polymer formation with greater efficiency than fetal hemoglobin (HbF; T.M.R. et al, unpublished data). This antisickling gene, βAS3-globin, was inserted into an SIN lentiviral vector33 to form the construct designated lenti/βAS3 (Figure 1B). The selection of β-globin promoter, enhancer, and LCR elements was based on our previous studies analyzing the expression of human β-globin genes in transgenic mice.34,36,47,48 Lenti/βAS3 contains the central polypurine tract/DNA flap for increased packaging efficiency, viral titer, and transduction efficiency49,50 and the woodchuck hepatitis virus post-transcriptional regulatory element (WPRE) that increases the efficiency of RNA processing and contributes to the production of full-length viral transcripts.51 Lenti/βAS3 was pseudotyped with the vesicular stomatitis virus G (VSV-G) glycoprotein and concentrated to a final titer of 1 × 108 infectious units/mL as described in “Materials and methods.”
Insertion of a potent antisickling human β-globin gene into a lentiviral vector. (A) Schematic of the human β-globin LCR and downstream genes. HS cores are indicated by arrows. Genes are illustrated by filled boxes and are represented according to scale. (B) The lentiviral/antisickling β-globin expression construct is shown. HS2 (1203 bp), HS3 (1213 bp), and HS4 (954 bp) sequences, the 3′ globin enhancer, the 266-bp β-globin promoter (βp) and the βAS3 globin gene are drawn to scale. The HIV-1 LTR is shown with a 3′ SIN deletion; ψ indicates packaging signal; SD and SA, splice donor and acceptor sites, respectively; RRE, Rev-responsive element; cPPT/CTS, central polypurine tract or DNA flap/central termination sequence; and WPRE, woodchuck hepatitis virus post-transcriptional regulatory element. (C) Lentiviral vector copy number determination. Lane 1 is the PCR product obtained from bone marrow of a KO-TG sickle mouse after amplification, labeled primer extension, and Bsu36I digestion; lanes 2, 3, and 4 are products of representative lenti/βAS3-transduced mice; and lane 5 is a knockout-transgenic animal expressing exclusively human HbAS3.
Insertion of a potent antisickling human β-globin gene into a lentiviral vector. (A) Schematic of the human β-globin LCR and downstream genes. HS cores are indicated by arrows. Genes are illustrated by filled boxes and are represented according to scale. (B) The lentiviral/antisickling β-globin expression construct is shown. HS2 (1203 bp), HS3 (1213 bp), and HS4 (954 bp) sequences, the 3′ globin enhancer, the 266-bp β-globin promoter (βp) and the βAS3 globin gene are drawn to scale. The HIV-1 LTR is shown with a 3′ SIN deletion; ψ indicates packaging signal; SD and SA, splice donor and acceptor sites, respectively; RRE, Rev-responsive element; cPPT/CTS, central polypurine tract or DNA flap/central termination sequence; and WPRE, woodchuck hepatitis virus post-transcriptional regulatory element. (C) Lentiviral vector copy number determination. Lane 1 is the PCR product obtained from bone marrow of a KO-TG sickle mouse after amplification, labeled primer extension, and Bsu36I digestion; lanes 2, 3, and 4 are products of representative lenti/βAS3-transduced mice; and lane 5 is a knockout-transgenic animal expressing exclusively human HbAS3.
Transduction and transplantation of Sca-1+c-Kit+Lin- SCD HSCs
As described (see “Introduction”), mobilization of bone marrow stem cells with cytokines such as G-CSF and SCF cannot be safely performed in sickle cell patients. Therefore, we used a transduction protocol that does not include mobilization.32 Bone marrow was isolated from untreated KO-TG-B6 SCD (sickle) mice, and HSCs that were positive for stem cell antigen (Sca-1+) and c-Kit+, and negative (or low) for hematopoietic lineage antigens (lin-/low) were isolated by preparative flow cytometry (Figure 2).52,53 Without cytokine prestimulation, 1000 Sca-1+, c-Kit+, lin-/low (KLS) stem cells were transduced for 4 hours with lenti/βAS3 at an MOI of 30. This relatively low amount of virus was used to minimize exposure of the animals to lentivirus and to reduce the possibility of insertional mutagenesis. Transduced HSCs were transplanted into lethally irradiated (1325 cGy), wild-type C57Bl/6 recipients and reconstitution was quantified by HPLC analysis of hemoglobins (Figure S1; see the Supplemental Figure link at the top of the online article on the Blood website). Animals that expressed more than 99% human hemoglobin 12 weeks after transplantation were identified and retained for long-term analysis. This high level of donor cell engraftment precludes artifactual amelioration of anemia resulting from the presence of residual murine RBCs.
Isolation of highly purified Sca-1+c-Kit+Lin- HSCs from sickle mice.WBM was sorted on a MACS column to obtain Sca-1-enriched cells. Three-color preparative FACS was then performed to isolate Sca-1+, c-Kit+, Lin-/low HSCs. Purified KLS cells satisfy gating requirements for R1 (A), R2 (D), and R3 (C). R4 (B) indicates the c-Kit+ and Lin-/low cell population.
Isolation of highly purified Sca-1+c-Kit+Lin- HSCs from sickle mice.WBM was sorted on a MACS column to obtain Sca-1-enriched cells. Three-color preparative FACS was then performed to isolate Sca-1+, c-Kit+, Lin-/low HSCs. Purified KLS cells satisfy gating requirements for R1 (A), R2 (D), and R3 (C). R4 (B) indicates the c-Kit+ and Lin-/low cell population.
Vector copy number was determined by allele-specific PCR of bone marrow DNA. Lenti/βAS3 was present at 2.2 ± 0.3 (SE) proviral units per transduced cell (Figure 1C).
Therapeutic expression levels of human βAS3in murine erythrocytes following lentiviral gene transfer into purified HSCs
At 5 to 7 months after transplantation, peripheral blood was collected from lenti/βAS3 and mock-transduced animals. Hemolysates were prepared and hemoglobins (HbS and HbAS3) were separated by IEF. All of the fully reconstituted animals expressed 20% to 25% HbAS3 and 75% to 80% HbS (Figure 3A). Bone marrow was isolated from several of these animals and transplanted into lethally irradiated secondary recipients. The last lane of Figure 3A (TP20) is a hemolysate from a representative secondary recipient 7 months after transplantation; HbAS3 is 20% of total hemoglobin. These results demonstrate that unmobilized, unstimulated HSCs are stably transduced for up to 14 months with lenti/βAS3.
Therapeutic βAS3-globin expression levels in murine erythrocytes following lentiviral gene delivery. (A) IEF of hemolysates from recipient mice at 5 to 7 months after transplantation. The first 4 lanes are human HbS, murine hemoglobin, human HbAS3, and mock-transduced controls. The next 5 lanes are 5 primary lenti/βAS3 mice reconstituted with more than 99% donor cells. The final lane is a representative secondary transplant at 4 months after transplantation. (B) Single-cell expression analysis of lenti/βAS3 reticulocytes. Following thiazole orange staining, reticulocytes were sorted by flow cytometry. mRNA was isolated from individual lysed cells, reverse transcribed, PCR amplified, radioactively labeled by primer extension, and digested with Bsu36I, which digests βAS3 but not βS. Data are from 13 representative reticulocytes. Population controls of 100 cells from the same transplant (TP), an HbAS3 knockout-transgenic (AS3), or a donor knockout-transgenic sickle mouse (S) are also shown. (C) Lentiviral vector copy number determination in bone marrow G/M, erythroid progenitors, and WBM from secondary recipients at 7 months after transplantation. G/M is granulocyte/macrophage (Gr1+ and CD11b/Mac1+), T is erythroid progenitor (Ter119+), and WBM is whole bone marrow.
Therapeutic βAS3-globin expression levels in murine erythrocytes following lentiviral gene delivery. (A) IEF of hemolysates from recipient mice at 5 to 7 months after transplantation. The first 4 lanes are human HbS, murine hemoglobin, human HbAS3, and mock-transduced controls. The next 5 lanes are 5 primary lenti/βAS3 mice reconstituted with more than 99% donor cells. The final lane is a representative secondary transplant at 4 months after transplantation. (B) Single-cell expression analysis of lenti/βAS3 reticulocytes. Following thiazole orange staining, reticulocytes were sorted by flow cytometry. mRNA was isolated from individual lysed cells, reverse transcribed, PCR amplified, radioactively labeled by primer extension, and digested with Bsu36I, which digests βAS3 but not βS. Data are from 13 representative reticulocytes. Population controls of 100 cells from the same transplant (TP), an HbAS3 knockout-transgenic (AS3), or a donor knockout-transgenic sickle mouse (S) are also shown. (C) Lentiviral vector copy number determination in bone marrow G/M, erythroid progenitors, and WBM from secondary recipients at 7 months after transplantation. G/M is granulocyte/macrophage (Gr1+ and CD11b/Mac1+), T is erythroid progenitor (Ter119+), and WBM is whole bone marrow.
The fraction of erythroid cells that express βAS3 was determined by single-cell, allele-specific RT-PCR. Reticulocytes were isolated by FACS and individual cells were analyzed for βAS3 and βS mRNA. The primers for βAS3 and βS amplification were identical, and PCR products were distinguished by digestion with Bsu36I, which cuts βAS3 but not βS amplicons. Figure 3B illustrates the results for several individual reticulocytes and for a population of cells from a representative lenti/βAS3 mouse. Eighty-five percent (17 of 20) of the reticulocytes that were examined contained βAS3 mRNA. Individual reticulocyte levels of human βAS3-globin mRNA ranged from a low of 10% to a high of 43% of human βS-globin mRNA. The level of βAS3-globin mRNA expression in the entire population was 24%, and this level is consistent with the level of HbAS3 detected in the IEF gel.
All secondary recipients expressed between 20% and 25% HbAS3 7 months after transplantation (see representative sample in Figure 3A). Figure 3C demonstrates that FACS-purified bone marrow granulocytes/macrophages (G/M; Gr1+/Mac1+), erythroid progenitors (T;Ter119+), and whole bone marrow (WBM) from 3 of these secondary recipients (7 months after transplantation) contain an average lenti/βAS3 copy number of 1.9. Similar vector copy numbers for G/Ms, erythroid progenitors, and WBM in individual recipients suggest that HSCs are transduced and that corrected erythroid progenitors are not selectively amplified in the marrow.
Correction of abnormal RBC morphology and hematologic parameters in Lenti/βAS3-corrected SCD mice
Figure 4 illustrates blood smears from animals given transplants with mock-transduced and lenti/βAS3-transduced sickle HSCs 5 months after transplantation. Many rigid, elongated cells are observed in the mock-transduced control (Figure 4A); however, no sickled cells are observed in lenti/βAS3 mice (Figure 4C-D showing 2 representative animals). Figure 4B shows a wild-type control. The blood smears of lenti/βAS3 animals also lack the anisocytosis, poikilocytosis, and polychromasia characteristic of the erythrocyte morphology observed in SCD mice and HbSS patients.11,39 Table 1 compares hematologic indices of control, sickle, mock-transduced, and lenti/βAS3-transduced mice. Lenti/βAS3 animals have a marked increase in RBC counts, hemoglobin levels, and hematocrit values, and a significantly reduced reticulocytosis compared with mock-transduced controls. The 46 g/L (4.6 g/dL) rise in hemogloblin level (27 to 73 g/L [2.7 to 7.3 g/dL]) was achieved with a lenti/βAS3 copy number of 2.2 proviral units per cell. This increase of 21 g/L/proviral copy (2.1 g/dL) compares favorably with the values reported for correction of another sickle mouse model by Pawliuk et al (19 g/L/copy [1.9 g/dL/copy])15 and for correction of a β-thalassemia mouse model by May et al (38 g/L/copy [3.8 g/dL/copy]),14 Rivella et al (23 g/L/copy [2.3 g/dL/copy]),54 Imren et al (15 g/L/copy [1.5 g/dL/copy]),16 and Persons et al (11 g/L/copy [1.1 g/dL/copy]).17 The last line of Table 1 demonstrates that secondary recipients at 7 months after transplantation retain the marked increases in RBC counts, hemogloblin concentrations, and hematocrit levels and reduced reticulocytosis compared with mock-transduced controls.
Correction of abnormal RBC morphology in lenti/βAS3rescued transplants. (A) Blood smear from a mock-transplanted animal with characteristic sickled erythrocytes and a pronounced reticulocytosis. (B-C) Two representative primary transplant recipients of βAS3-transduced stem cells. No sickled cells were observed in any fields examined. (D) Wild-type C57Bl6 control. Original magnification × 120. Blood smears were stained with Wright-Giemsa.
Correction of abnormal RBC morphology in lenti/βAS3rescued transplants. (A) Blood smear from a mock-transplanted animal with characteristic sickled erythrocytes and a pronounced reticulocytosis. (B-C) Two representative primary transplant recipients of βAS3-transduced stem cells. No sickled cells were observed in any fields examined. (D) Wild-type C57Bl6 control. Original magnification × 120. Blood smears were stained with Wright-Giemsa.
Sickled erythrocytes are not observed in blood smears or in tissues of lenti/βAS3 mice; however, the animals remain significantly anemic with hemoglobin concentrations of 73 g/L (7.3 g/dL). This persistent anemia despite a 46-g/L (4.6-g/dL) rise in hemoglobin level is a consequence of the extremely low baseline hemoglobin concentrations in sickle animals that are bred onto the C57B/6 background (27 g/L [2.7 g/dL]). We do not know the reasons for this strain-dependent, severe anemia but we are currently examining genes that modify disease severity. A 46-g/L (4.6-g/dL) increase in hemoglobin in human sickle patients would dramatically reduce anemia.
Amelioration of spleen, liver, and kidney pathology; restoration of kidney function in sickle mice
Recipients of lenti/βAS3-transduced sickle HSCs developed little spleen, liver, and kidney pathology compared with recipients of mock-transduced cells. Histologic sections of wild-type, mock-transduced, and lenti/βAS3 animals are shown in Figure 5A. The spleens of mock-transduced mice are characterized by a massive expansion of red pulp, dramatic pooling of sinusoidal erythrocytes, vaso-occlusion, and a complete loss of lymphoid follicular structure. In lenti/βAS3-transduced mice, normal splenic red and white pulp is observed and virtually no pools of sickle erythrocytes or infarcts are evident. In addition, splenomegaly is substantially diminished in lenti/βAS3 mice (Figure 5B); lenti/βAS3 spleens are approximately 0.7% of total body weight compared with mock-transduced spleens that are almost 2.0% of body weight.
Amelioration of spleen, liver, and kidney pathology in lenti/βAS3mice.(A) Spleen, liver, and kidney sections were analyzed at low (original magnifications are × 10 for spleen and kidney and × 40 for liver; top 3 rows and bottom row) and high magnification (original magnification, × 100; bottom rows for spleen and liver and the middle row for kidney). In lenti/βAS3-transduced mice, normal splenic red and white pulp is observed and virtually no pools of sickle erythrocytes or infarcts are evident. In livers of lenti/βAS3 animals, focal areas of necrosis and aggregation of sickled erythrocytes are not observed; also, extramedullary hematopoiesis and hemosiderin deposition are absent. Kidneys of lenti/βAS3 mice appear normal and free of the disruptive vascular RBC pooling and hemosiderin deposits observed in mock-treated animals. (B) Correction of splenomegaly in lenti/βAS3-transduced mice. All sections except the bottom panel were stained with hematoxylin-eosin; the bottom panel was stained with Gomori iron.
Amelioration of spleen, liver, and kidney pathology in lenti/βAS3mice.(A) Spleen, liver, and kidney sections were analyzed at low (original magnifications are × 10 for spleen and kidney and × 40 for liver; top 3 rows and bottom row) and high magnification (original magnification, × 100; bottom rows for spleen and liver and the middle row for kidney). In lenti/βAS3-transduced mice, normal splenic red and white pulp is observed and virtually no pools of sickle erythrocytes or infarcts are evident. In livers of lenti/βAS3 animals, focal areas of necrosis and aggregation of sickled erythrocytes are not observed; also, extramedullary hematopoiesis and hemosiderin deposition are absent. Kidneys of lenti/βAS3 mice appear normal and free of the disruptive vascular RBC pooling and hemosiderin deposits observed in mock-treated animals. (B) Correction of splenomegaly in lenti/βAS3-transduced mice. All sections except the bottom panel were stained with hematoxylin-eosin; the bottom panel was stained with Gomori iron.
Livers of mock-transduced animals are characterized by focal areas of necrosis and pronounced congestion of the intrahepatic vasculature with aggregates of sickled RBCs. Erythroid progenitors are evident in the sinusoids and this extramedullary hematopoiesis is indicative of severe anemia. There is also abundant hemosiderin deposition subsequent to Kupffer cell erythrophagocytosis. In lenti/βAS3 animals, focal areas of necrosis and aggregation of sickled erythrocytes are not observed; also, extramedullary hematopoiesis and hemosiderin deposition are absent.
In the kidneys of mock-transduced mice, engorgement and occlusion of blood vessels result in vascular, tubular, and glomerular changes. Sequestration and occlusion are most obvious at the corticomedullary junction where dilated capillaries are easily observed in this region of reduced oxygen tension. Reduced medullary blood flow in HbSS patients causes extensive tubular damage that results in hyposthenuria, and this same loss of ability to concentrate urine is observed in the sickle mice. Kidneys of mock-transduced animals also accumulate abundant hemosiderin in the cortical region and these aggregates are easily visualized with Gomori iron staining (Figure 5A, bottom panels). In contrast, kidneys of lenti/βAS3 mice appear normal and free of the disruptive vascular RBC pooling and hemosiderin deposits observed in mock-treated animals. Most importantly, urine-concentrating ability is almost completely restored in lenti/βAS3 mice and this restoration is maintained in secondary recipients at 7 months after transplantation (Table 1).
Discussion
We have corrected our mouse model of SCD using minimal amounts of a SIN lentiviral-based vector designed to deliver a novel, antisickling human β-globin gene into purified HSCs. The correction was accomplished with a transduction protocol that should be translatable to human patients. The protocol does not include mobilization of bone marrow or cytokine stimulation of HSCs. Bone marrow mobilization protocols are not safe for sickle cell patients because rapid increases in leukopoiesis are associated with vascular crises that can result in death.18,19 Therefore, we collected bone marrow from animals in the absence of pretreatment with 5-FU or G-CSF. We also used quiescent HSCs that were not stimulated with cytokines prior to or during transduction. Most, if not all, cytokine pretreatment protocols induce some measure of HSC differentiation and loss of long-term repopulating activity21-25 ; therefore, autologous and allogenic bone marrow transplantation protocols in humans typically do not use cytokine pretreatments.13 Our previous results with a lenti/CMV-GFP vector demonstrated that efficient lentiviral transduction of purified HSCs does not require cytokine induction of cell cycle progression32 ; therefore, we used the same protocol in the lenti/βAS3 studies described in this paper.
At 5 to 7 months after transplantation, we analyzed lenti/βAS3 mice that were reconstituted with more than 99% donor cells, and all of these animals were corrected; all mock-transduced controls developed severe disease. Secondary lenti/βAS3 transplants were also corrected for at least 7 months after transplantation. These results demonstrate that long-term repopulating cells are stably transduced. Interestingly, 75% to 85% of reticulocytes in these animals synthesized βAS3 mRNA. This nearly pancellular expression was unexpected using a nonmobilizing transduction protocol in the absence of cytokine prestimulation. These results suggest that transduction of relatively quiescent HSCs was efficient with our protocol.
Hematologic values of mice given transplants with lenti/βAS3-transduced HSCs were dramatically improved. RBC counts, hematocrit values, and hemoglobin levels were markedly increased and reticulocyte numbers were reduced from 69% to 14%. Although some anemia was still evident in these animals, the mice mimicked sickle patients with hereditary persistence of fetal hemoglobin (HPFH). HPFH patients who synthesize 20% HbF typically have mild disease and lead relatively normal lives.
Tissue pathology was almost completely corrected in the lenti/βAS3-transduced animals. No splenic infarction, liver necrosis, or kidney corticomedullary damage was observed, and urine-concentrating ability was restored to normal levels. These results demonstrate that a single dose of lenti/βAS3 can correct SCD and that this correction is stable for the lifetime of the animal and in secondary transplant recipients.
Concerns about viral transduction of hematopoietic cells have recently been raised by the development of leukemia in 2 patients with severe combined immunodeficiency (SCID) who were treated by gene therapy.55,56 Insertion of the retroviral vector near the LMO-2 gene apparently stimulated expression of this proto-oncogene that normally regulates crucial steps in hematopoiesis.57 Activation of oncogenes by enhancer sequences present in the LTRs of retroviruses has been reported in the literature58 and these LTR enhancers can activate genes at distances approaching 100 kb.59 Although insertional activation of proto-oncogenes by lentiviral LTR enhancers has not been reported, we used a SIN lentiviral vector in our studies to minimize these events.
We also attempted to minimize insertional activation/mutagenesis by limiting the total amount of virus in our transduction protocol. Low levels of viral exposure were possible because highly purified HSCs were transduced instead of whole bone marrow or partially purified cells. At least 3000 times less lentivirus was used compared with previous protocols by transducing and transplanting only 1000 Sca-1+, c-Kit+, Lin-/low cells. This procedure limits vector integration into committed progenitors and mature cells that are abundant in total mononuclear cell preparations. Mature donor T and B cells can persist for long periods of time in transplant recipients. These cells replicate actively and are responsible for the acquisition of donor immunity in allogeneic recipients.60-62 Vector insertions in these cells and in other committed lineages, which can be transformed,63,64 may increase the risk of insertional activation of proto-oncogenes such as LMO-2. We did not observe leukemias in any of our primary or secondary transplant recipients.
Finally, the use of low levels of virus in our transduction protocol may also minimize the probability of generating replication competent lentivirus. Although the probability of recombination between the lentiviral vector and endogenous viral-like sequences is low, a 3000-fold decrease in viral exposure should reduce the frequency of recombination even further.
In summary, we have corrected SCD disease in a mouse model that mimics most if not all of the pathology of this severe disease. Our transduction protocol, which uses highly purified, unmobilized HSCs and minimal exposure to the self-inactivating lenti/βAS3 vector, may be effectively and safely translated to human patients.
Supported by National Institutes of Health (NIH) Predoctoral Fellowship Training Grant 5 T32 CA09467 (D.N.L.) and NIH Grant HL57619 (T.M.T.).
Prepublished online as Blood First Edition Paper, August 21, 2003; DOI 10.1182/blood-2003-04-1251.
The online version of the article contains a data supplement.
The publication costs of this article were defrayed in part by page charge payment. Therefore, and solely to indicate this fact, this article is hereby marked “advertisement” in accordance with 18 U.S.C. section 1734.
We thank Dr Didier Trono and helpful members of his laboratory, especially Dr Patrick Salmon. We would like to thank Enid Keyser in the Arthritis and Musculoskeletal Center Flow Cytometry Core Facility and Marion Spell in the Center for AIDS Research Flow Cytometry Facility for stem cell and reticulocyte sorting. We also thank members of the Townes laboratory for many helpful discussions.